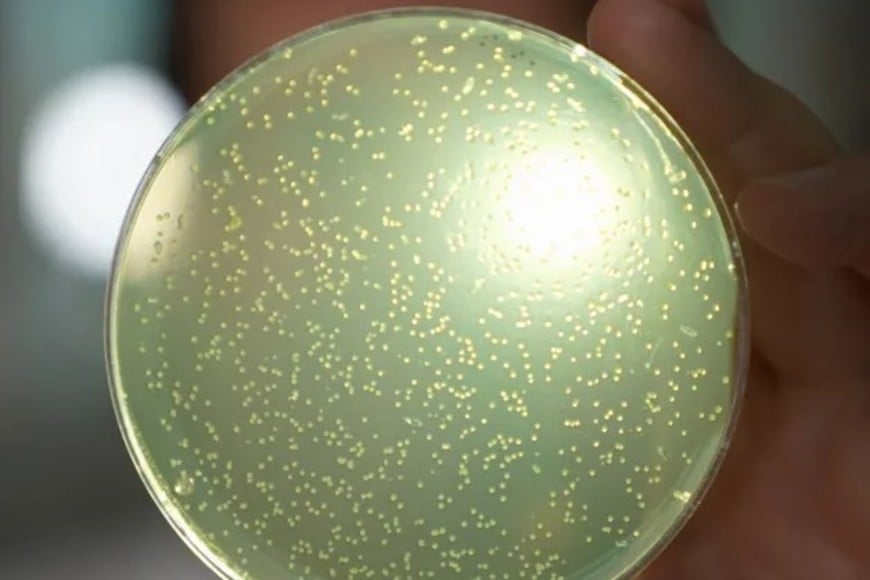

¿Nos preocupamos? Comenzaron un polémico proyecto para crear ADN humano artificial
La investigación ha sido tabú hasta ahora debido a la preocupación de que pudiera dar lugar a bebés de diseño o a cambios imprevistos para las generaciones futuras.
Comenzaron los trabajos en un controvertido proyecto para crear los componentes básicos de la vida humana desde cero, en lo que se cree que es una primicia mundial. La investigación ha sido tabú hasta ahora debido a la preocupación de que pudiera dar lugar a bebés de diseño o a cambios imprevistos para las generaciones futuras.
Wellcome Trust apuesta al futuro de la biología sintética
Pero ahora la organización benéfica médica más grande del mundo, Wellcome Trust, ha donado £10 millones iniciales para iniciar el proyecto y dice que tiene el potencial de hacer más bien que mal al acelerar los tratamientos para muchas enfermedades incurables.

El doctor Julian Sale, del Laboratorio de Biología Molecular MRC en Cambridge, que forma parte del proyecto, dijo a BBC News que la investigación era el próximo gran salto en biología. "El cielo es el límite. Buscamos terapias que mejoren la vida de las personas a medida que envejecen, que conduzcan a un envejecimiento más saludable con menos enfermedades a medida que envejecen.
"Buscamos utilizar este enfoque para generar células resistentes a las enfermedades que podamos usar para repoblar órganos dañados, por ejemplo, el hígado, el corazón e incluso el sistema inmunológico", explicó. Pero los críticos temen que la investigación abra el camino a investigadores sin escrúpulos que buscan crear humanos mejorados o modificados.
El Dr. Pat Thomas, director del grupo de campaña Beyond GM, dijo: "Nos gusta pensar que todos los científicos están allí para hacer el bien, pero la ciencia puede reutilizarse para hacer daño y para la guerra". Los detalles del proyecto fueron proporcionados a BBC News en el 25 aniversario de la finalización del Proyecto Genoma Humano, que mapeó las moléculas del ADN humano y también fue financiado en gran parte por Wellcome.
Cada célula de nuestro cuerpo contiene una molécula llamada ADN, que contiene la información genética necesaria. El ADN se compone de cuatro bloques mucho más pequeños, A, G, C y T, que se repiten una y otra vez en diversas combinaciones. Sorprendentemente, contiene toda la información genética que nos define físicamente.
El Proyecto Genoma Humano permitió a los científicos leer todos los genes humanos como si fueran un código de barras. El nuevo trabajo en marcha, denominado Proyecto Genoma Humano Sintético, podría suponer un gran avance: permitirá a los investigadores no solo leer una molécula de ADN, sino crear partes de ella —quizás algún día la totalidad— molécula a molécula desde cero.
El primer objetivo de los científicos es desarrollar maneras de construir bloques cada vez más grandes de ADN humano, hasta el punto de construir sintéticamente un cromosoma humano. Estos contienen los genes que rigen nuestro desarrollo, reparación y mantenimiento. Estos pueden luego estudiarse y experimentarse para aprender más sobre cómo los genes y el ADN regulan nuestros cuerpos.
Muchas enfermedades ocurren cuando estos genes fallan, por lo que los estudios podrían conducir a mejores tratamientos, según el profesor Matthew Hurles, director del Wellcome Sanger Institute, que secuenció la mayor proporción del genoma humano. "Construir ADN desde cero nos permite probar cómo funciona realmente y probar nuevas teorías, porque actualmente solo podemos hacerlo modificando el ADN que ya existe en los sistemas vivos".
El trabajo del proyecto se limitará a tubos de ensayo y placas, y no se intentará crear vida sintética. Sin embargo, la tecnología brindará a los investigadores un control sin precedentes sobre los sistemas vivos humanos.
Preocupaciones sobre la manipulación genética y sus implicancias
Y aunque el proyecto busca beneficios médicos, no hay nada que impida que científicos sin escrúpulos hagan mal uso de la tecnología. Podrían, por ejemplo, intentar crear armas biológicas, humanos mejorados o incluso criaturas que tengan ADN humano, según el profesor Bill Earnshaw, un científico genético muy respetado en la Universidad de Edimburgo que diseñó un método para crear cromosomas humanos artificiales.
"El genio ya salió de la lámpara", declaró a BBC News. "Podríamos tener un conjunto de restricciones ahora, pero si una organización con acceso a la maquinaria adecuada decidiera empezar a sintetizar algo, no creo que pudiéramos detenerlo". A la Sra. Thomas le preocupa cómo las empresas sanitarias que desarrollan tratamientos surgidos de la investigación comercializarán la tecnología.
Si logramos crear partes corporales sintéticas o incluso personas sintéticas, ¿quién será su propietario? ¿Y quién será el propietario de los datos de estas creaciones? Dado el posible uso indebido de la tecnología, la pregunta para Wellcome es por qué decidieron financiarla. La decisión no fue a la ligera, según el Dr. Tom Collins, quien autorizó la financiación. "Nos preguntamos cuál fue el coste de la inacción", dijo a BBC News.
Esta tecnología se desarrollará algún día, así que al hacerlo ahora, al menos intentamos hacerlo de la forma más responsable posible y abordar las cuestiones éticas y morales con la mayor franqueza posible.
Un programa dedicado a las ciencias sociales se desarrollará en paralelo al desarrollo científico del proyecto y estará dirigido por la profesora Joy Zhang, socióloga de la Universidad de Kent. "Queremos conocer la opinión de expertos, científicos sociales y, especialmente, del público sobre cómo se relacionan con la tecnología y cómo puede serles beneficiosa y, lo que es más importante, qué preguntas e inquietudes tienen", dijo.
Con información de BBC y El Litoral

/https://radiorafaelacdn.eleco.com.ar/media/2025/06/crear_adn.jpg)
Para comentar, debés estar registradoPor favor, iniciá sesión